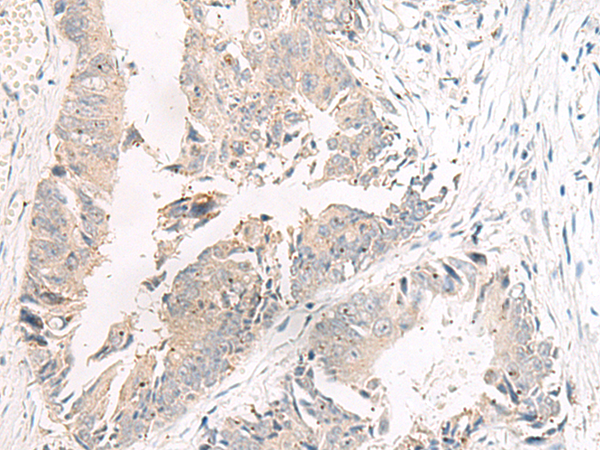

|
Background: |
This gene encodes an essential cofactor of the blood coagulation cascade. This factor circulates in plasma, and is converted to the active form by the release of the activation peptide by thrombin during coagulation. This generates a heavy chain and a light chain which are held together by calcium ions. The activated protein is a cofactor that participates with activated coagulation factor X to activate prothrombin to thrombin. Defects in this gene result in either an autosomal recessive hemorrhagic diathesis or an autosomal dominant form of thrombophilia, which is known as activated protein C resistance. |
|
Applications: |
ELISA, IHC |
|
Name of antibody: |
F5(Coagulation factor V light chain) |
|
Immunogen: |
Synthetic peptide of human F5(Coagulation factor V light chain) |
|
Full name: |
coagulation factor V |
|
Synonyms: |
FVL; PCCF; THPH2; RPRGL1 |
|
SwissProt: |
P12259 |
|
ELISA Recommended dilution: |
5000-10000 |
|
IHC positive control: |
Human colorectal cancer |
|
IHC Recommend dilution: |
20-100 |
購物車
購物車 幫助
幫助
 021-54845833/15800441009
021-54845833/15800441009
